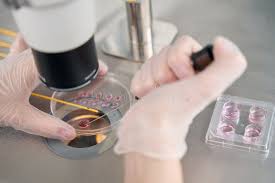

Dr. Vamberto Maia Filho
Ginecologia e Reprodução Humana

Dr. Vamberto Maia Filho
Ginecologia e Reprodução Humana
Concluí a graduação e fiz duas residências médicas (Ginecologia-Obstetrícia e Reprodução Humana) no Recife. Como chefe da residência, reformulei o atendimento aos pacientes, inauguramos cirurgias por vídeo na emergência do hospital e ainda participei do 1º bebê por Fertilização in vitro do SUS na capital pernambucana, o que me enche de orgulho. Vim para São Paulo para realizar meu doutorado pela Universidade Federal de São Paulo (Unifesp) e, na instituição, fui professor convidado e preceptor da disciplina de ginecologia endócrina por 11 anos.
Relatos que Tocam o Coração
Filhos – Histórias Inspiradoras
“Filhos – Histórias Inspiradoras” reúne histórias emocionantes de pacientes que, com coragem e determinação, superaram obstáculos para se tornarem mães. Este livro é uma homenagem à resiliência e ao amor incondicional que a maternidade desperta.
Conheça os Tipos de Tratamentos
FIV (FERTILIZAÇÃO IN VITRO)
A ideia era ambiciosa. Fazer um bebê fora do útero e transferir para o útero da futura mãe. Coube ao Dr. Robert Edwards (Prêmio Nobel de Medicina) a primazia do primeiro bebê de Proveta (nome que se usou a época hoje designado fertilização in vitro ou FIV), a hoje já mãe Louise Brown. A FIV é a técnica em reprodução humana mais avançada e que traduz em maiores taxas de êxito gestacional.
De uma forma simplista usamos medicações para estimulação ovariana que num ciclo natural produz apenas um folículo (em cada folículo um óvulo). Assim conseguimos maiores números o que nos permite mais chances de obter a gravidez. O processo se divide em estimulação ovariana, maturação dos folículos, coleta dos óvulos, fertilização e transferência de embriões.
Conheça os principais
Tratamentos para Fertilidade
Marque um consulta para que possamos analisar seu caso e indicar o melhor tratamento baseado na sua condição clínica.
ㅤ
Confira aqui as principais
Dúvidas sobre Infertilidade
Na mídia com
Dr. Vamberto Maia Filho
Estamos sempre esclarecendo dúvidas e trocando ideias na linguagem mais simples possível. Que tal tomar um cafezinho e ver / ouvir nossos conteúdos?
Sites e Blogs
Imprensa
Matérias publicadas:
- Revista Crescer: Ocitocina: qual é o papel do hormônio da amamentação
- Estado de Minas: Como a reprodução humana pode ajudar a realizar o sonho da paternidade
- Guia do Bebê: Adoção de embrião